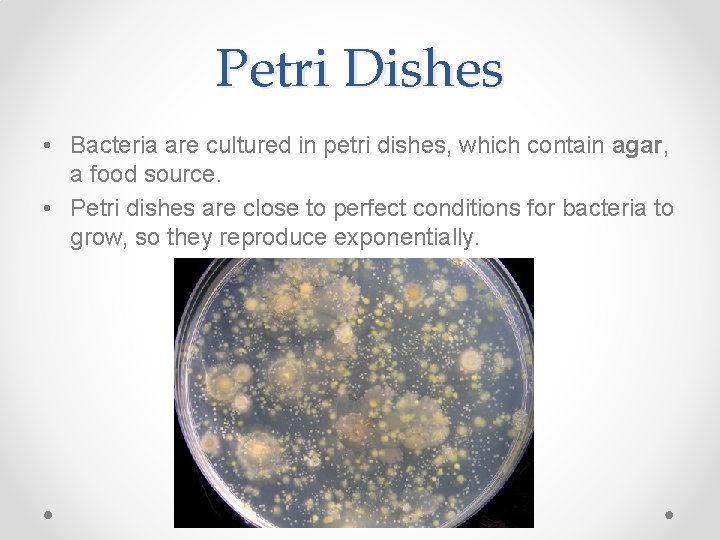
Petri Dishes • Bacteria are cultured in petri dishes, which contain agar, a food

Origin of Life Prokaryotic Cells Introduction to Biology

Origin of Life Prokaryotic Cells Introduction to Biology James Dauray

Origin of Cellular Life • The Earth formed about 4. 6 billion years ago. o For about 500 million years, the Earth was continually bombarded by chunks of rock and ice in the solar system. • The early atmosphere of Earth contained: o o o Water vapor H 2 O Nitrogen N 2 Carbon dioxide CO 2 Methane CH 4 Ammonia NH 3

Origin of Cellular Life • How did life arise from such a harsh environment? • Two scientists designed a model of what conditions were like on Earth at this time. o This is called the Miller-Urey Apparatus

Miller-Urey Apparatus • This apparatus simulated three important conditions on Earth: – – – The high amount of lightning Heat and gases released by volcanic activity Water vapor present in the atmosphere.

Results of Miller-Urey Apparatus • Simple compounds including water (H 2 O), methane (CH 4), ammonia (NH 3), and hydrogen (H 2) were used to simulate the atmosphere. • After 2 weeks, 10 -15% of the carbon had been used to form sugars, amino acids, and parts of nucleic acids. o These simple organic compounds could have produced the proteins, lipids, and carbohydrates that make up life today.

The First Cells • The first life forms on Earth were likely single-celled prokaryotic organisms. • Prokaryotic organisms are single-celled organisms that do not have a nucleus. o Their DNA or RNA is usually floating freely inside the cell. • Prokaryotic cells also do not have any membrane bound organelles.

• Most prokaryotes are microscopic, but what they lack in size they make up for in numbers. • There are more in a handful of fertile soil than the number of people who ever lived. • Prokaryotes thrive almost everywhere, including places too acidic, too salty, too cold, or too hot for most other organisms • They have an astonishing genetic diversity


Prokaryotic Energy Sources • Prokaryotes are able to get the energy they need for life from four different sources: o o • • Photoautotrophy Chemoautotrophy Photoheterotrophy Chemoheterotrophy “Photo” means light. “Chemo” means inorganic (non-living) chemicals. “Auto” means self. “Hetero” means different.


Relationships to Oxygen • Prokaryotic metabolism varies with respect to oxygen: o Obligate aerobes require oxygen o Facultative anaerobes can survive with or without oxygen o Obligate anaerobes are poisoned by oxygen

Archaea • Archaea are prokaryotic organisms that are very similar to bacteria in size and structure. • Bacteria and archaea likely evolved separately from the original life forms on Earth. • Key differences between bacteria and archaea: o Archaea can survive in extremely hot, cold, and salty environments. o Archaea are not affected by many antibiotics. o Archaea are obligate anaerobes; they can only survive in oxygen-free environments.

• Archaea can be classified by the type of environment they live in: o Extreme thermophiles thrive in very hot environments o Extreme halophiles live in high saline environments o Acidophiles live in environments with a very low p. H (high amounts of acid).


Reproduction • Prokaryotes reproduce quickly by binary fission and can divide every 1– 3 hours. o Binary fission is asexual reproduction and produces exact clones of the original bacteria. • Many prokaryotes form endospores, which can remain viable in harsh conditions for centuries

Reproduction • Prokaryotes are able to reproduce so quickly that under the right conditions they grow exponentially. • Exponential growth is when the population increases at a faster and faster rate. • This only occurs if all the needs of the bacteria culture are met (food, space, etc).
Petri Dishes • Bacteria are cultured in petri dishes, which contain agar, a food source. • Petri dishes are close to perfect conditions for bacteria to grow, so they reproduce exponentially.

• Prokaryotes like bacteria are able to evolve much more quickly than multicellular organisms. o They reproduce quickly. o Their genome is small, so a single mutation can change a bacteria drastically. o Prokaryotes are able to exchange plasmids with each other through pili.

Bacterial Shapes • Most prokaryotes are unicellular, although some species form colonies • Prokaryotic cells have a variety of shapes • The three most common of which are: o Coccus – Spherical o Bacillus – Rod-shaped o Spirilla – Spiral-shaped Video: Tubeworms

LE 27 -2 1 µm Spherical (cocci) 2 µm Rod-shaped (bacilli) 5 µm Spiral

Pili Nucleoid Ribosomes Plasma membrane Bacterial chromosome Cell wall Capsule 0. 5 µm Flagella A typical rod-shaped bacterium A thin section through the bacterium Bacillus coagulans (TEM)

• Most prokaryotes have a ring of DNA that is not surrounded by a membrane. o No nucleus. o DNA is kept within a nucleoid region instead. • Some species of bacteria also have smaller rings of DNA called plasmids. o These can be exchanged between invididuals. • DNA provides instructions to ribosomes, which produce any proteins the bacteria need.

LE 27 -8 Chromosome 1 µm

Internal Structures • Prokaryotic cells do not have membrane-bound organelles. o Ex: Chloroplast, mitochondria • However, some prokaryotes have special membranes that perform some of the same functions. o Thylakoid membranes enable photosynthesis o Respiratory membranes enable the use of oxygen to break down nutrients into ATP.

LE 27 -7 1 µm 0. 2 µm Respiratory membrane Thylakoid membranes Aerobic prokaryote Photosynthetic prokaryote

Cell-Surface Structures • An important feature of nearly all prokaryotic cells is their cell wall. • The cell wall… o Maintains cell shape o Provides physical protection o Prevents the cell from bursting in a hypotonic environment

• The cell wall of many prokaryotes is covered by a capsule, a layer of polysaccharides that protect them from being caught by white blood cells. Capsule

Fimbriae • Some prokaryotes have fimbriae and pili, which allow them to stick to their growing surface or attach to other prokaryotes to exchange genes. .

Motility • Most motile bacteria propel themselves by flagella. • In the environment, many bacteria exhibit the ability to move toward or away from certain stimuli Video: Prokaryotic Flagella (Salmonella typhimurium)

LE 27 -6 Flagellum Filament 50 nm Cell wall Hook Basal apparatus Plasma membrane

Importance of Prokaryotes • Prokaryotes are so important to the biosphere that if they were to disappear, most other life would not be able to survive.

Symbiotic Relationships • Symbiotic relationships are when two organisms live close together. • In mutualism, both symbiotic organisms benefit o Example: Bacteria that live in deep-sea fish, producing bioluminescence. • In commensalism, one organism benefits while neither harming nor helping the other. o Example: Most of the bacteria on human skin

Nitrogen Metabolism • Prokaryotes also need nitrogen to build amino acids and proteins. • One common source of nitrogen is called nitrogen fixation, where prokaryotes convert atmospheric nitrogen to ammonia. • Some plants, called legumes, have nodules in their roots that contain bacteria to help them fix nitrogen.

Chemical Recycling • Prokaryotes help recycle elements needed for life between living and nonliving parts of the ecosystem. • Heterotrophic prokaryotes function as decomposers, breaking down corpses, dead vegetation, and waste products into smaller molecules that can be used by other living things.

Bioluminescence • Some bacteria produce light as a result of their internal chemical reactions. • Other animals have formed mutualistic relationships with these bacteria to take advantage of this bioluminescence.

Harmful Bacteria • In parasitism, one organism, called a parasite, benefits at the expense of the host o Example: The bacteria that causes strep throat. • Not all prokaryotes are harmful, but some are human pathogens – they cause disease.

Pathogenic Prokaryotes • Prokaryotes cause about half of all human diseases • Lyme disease is one example.

• Pathogenic prokaryotes typically cause disease by releasing exotoxins or endotoxins • Exotoxins are released externally by the bacteria, often as waste products. o Example: Botulism, tetanus, anthrax • Endotoxins are released only when bacteria die and their cell walls break down o Example: Meningitis

Antibiotics • Antibiotics are anti-bacterial chemicals that originally came from mold. • Each antibiotic works in different ways. o Penicillin disrupts the bacteria’s ability to produce a cell wall, causing it to burst due to an influx of water into its cytoplasm.

Antibiotic Resistance • Bacteria can mutate and evolve quickly, due to their small size and fast reproduction rate. • Sometimes, a mutation will result in their ability to resist the action of antibiotics. o Over time, this mutation can spread throughout an entire colony, creating a strain of antibiotic-resistant bacteria. • Resistant bacteria will not be affected by the antibiotics in the same way.
- Slides: 40